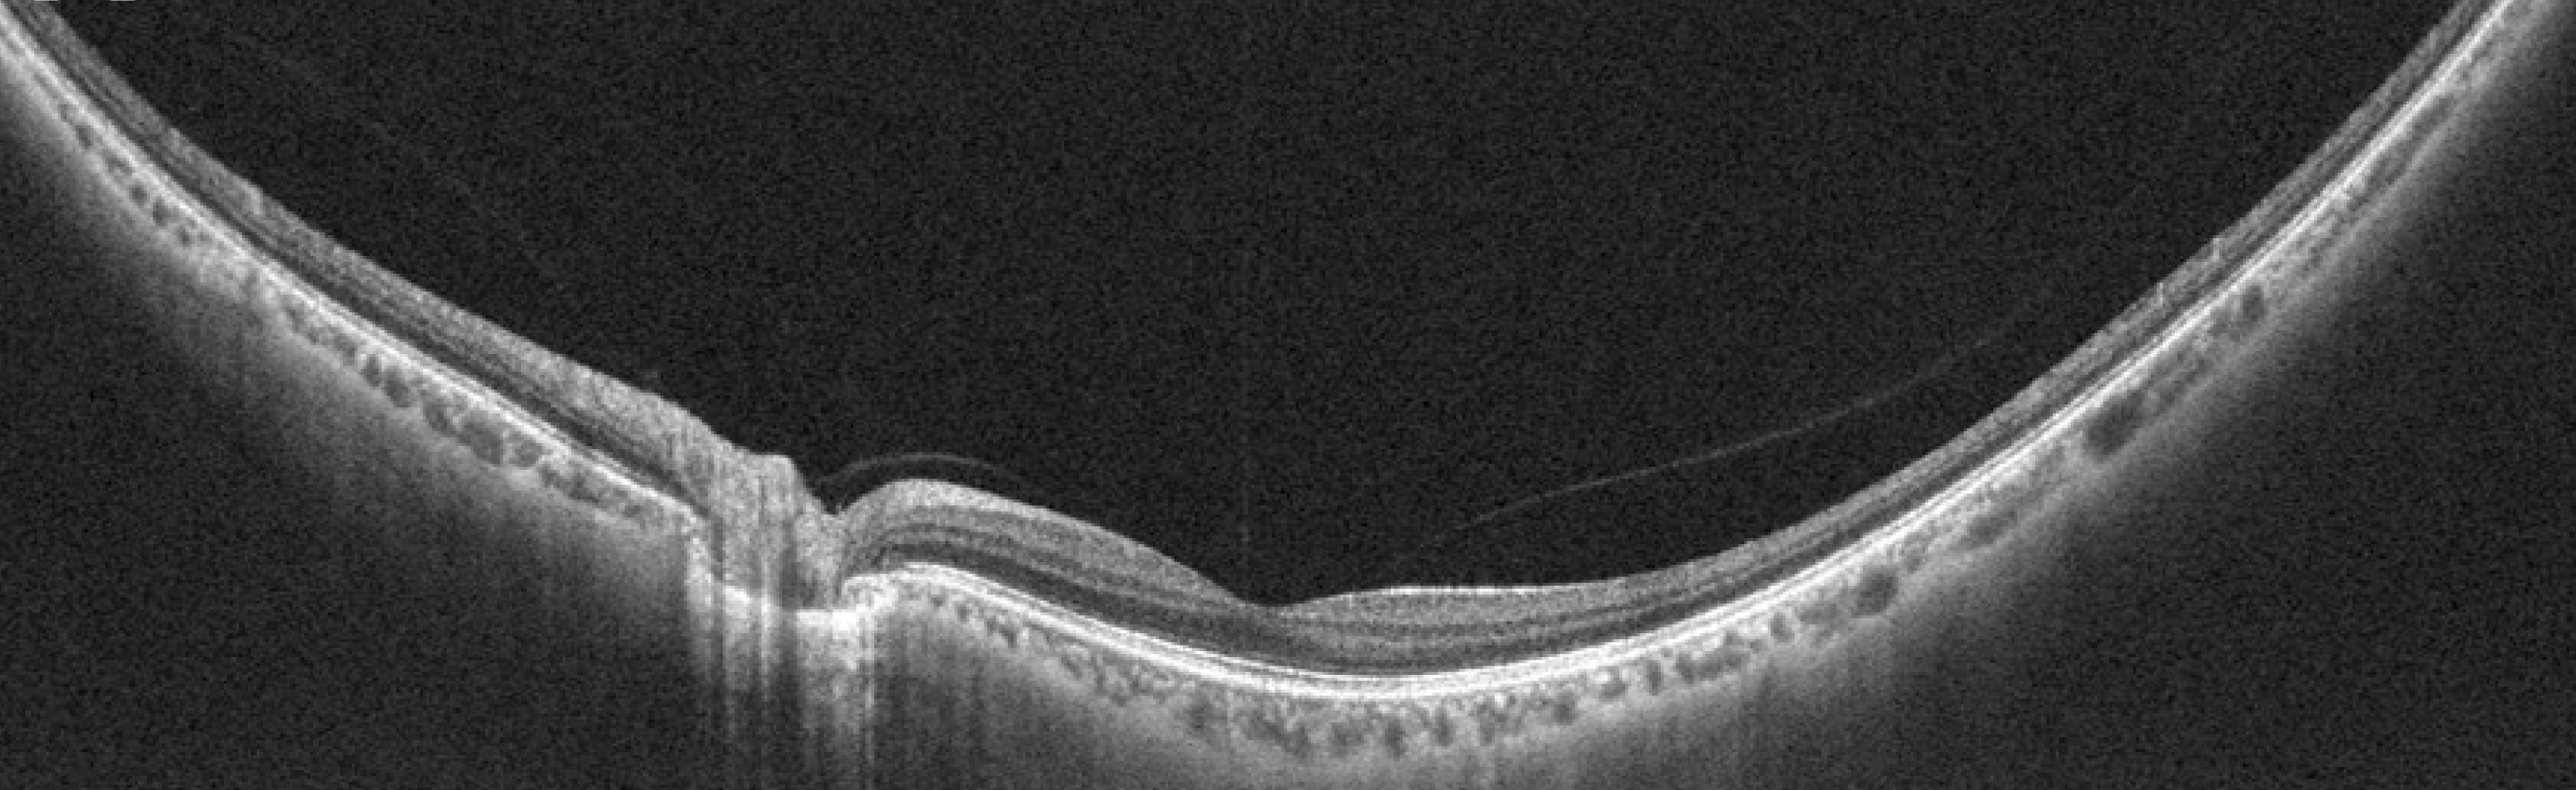

OCT Atlas is free resource developed for eye care students and professionals to refresh their skills in interpreting optical coherence tomography (OCT) scans.
Contributors:
- Konstantin Astafurov, MD PhD - original concept, programming, design
- Nicholas Heller, BS - contributor of cases
- Joseph Raevis, MD - contributor of cases
If you have any suggestions, questions or comments, please post them below